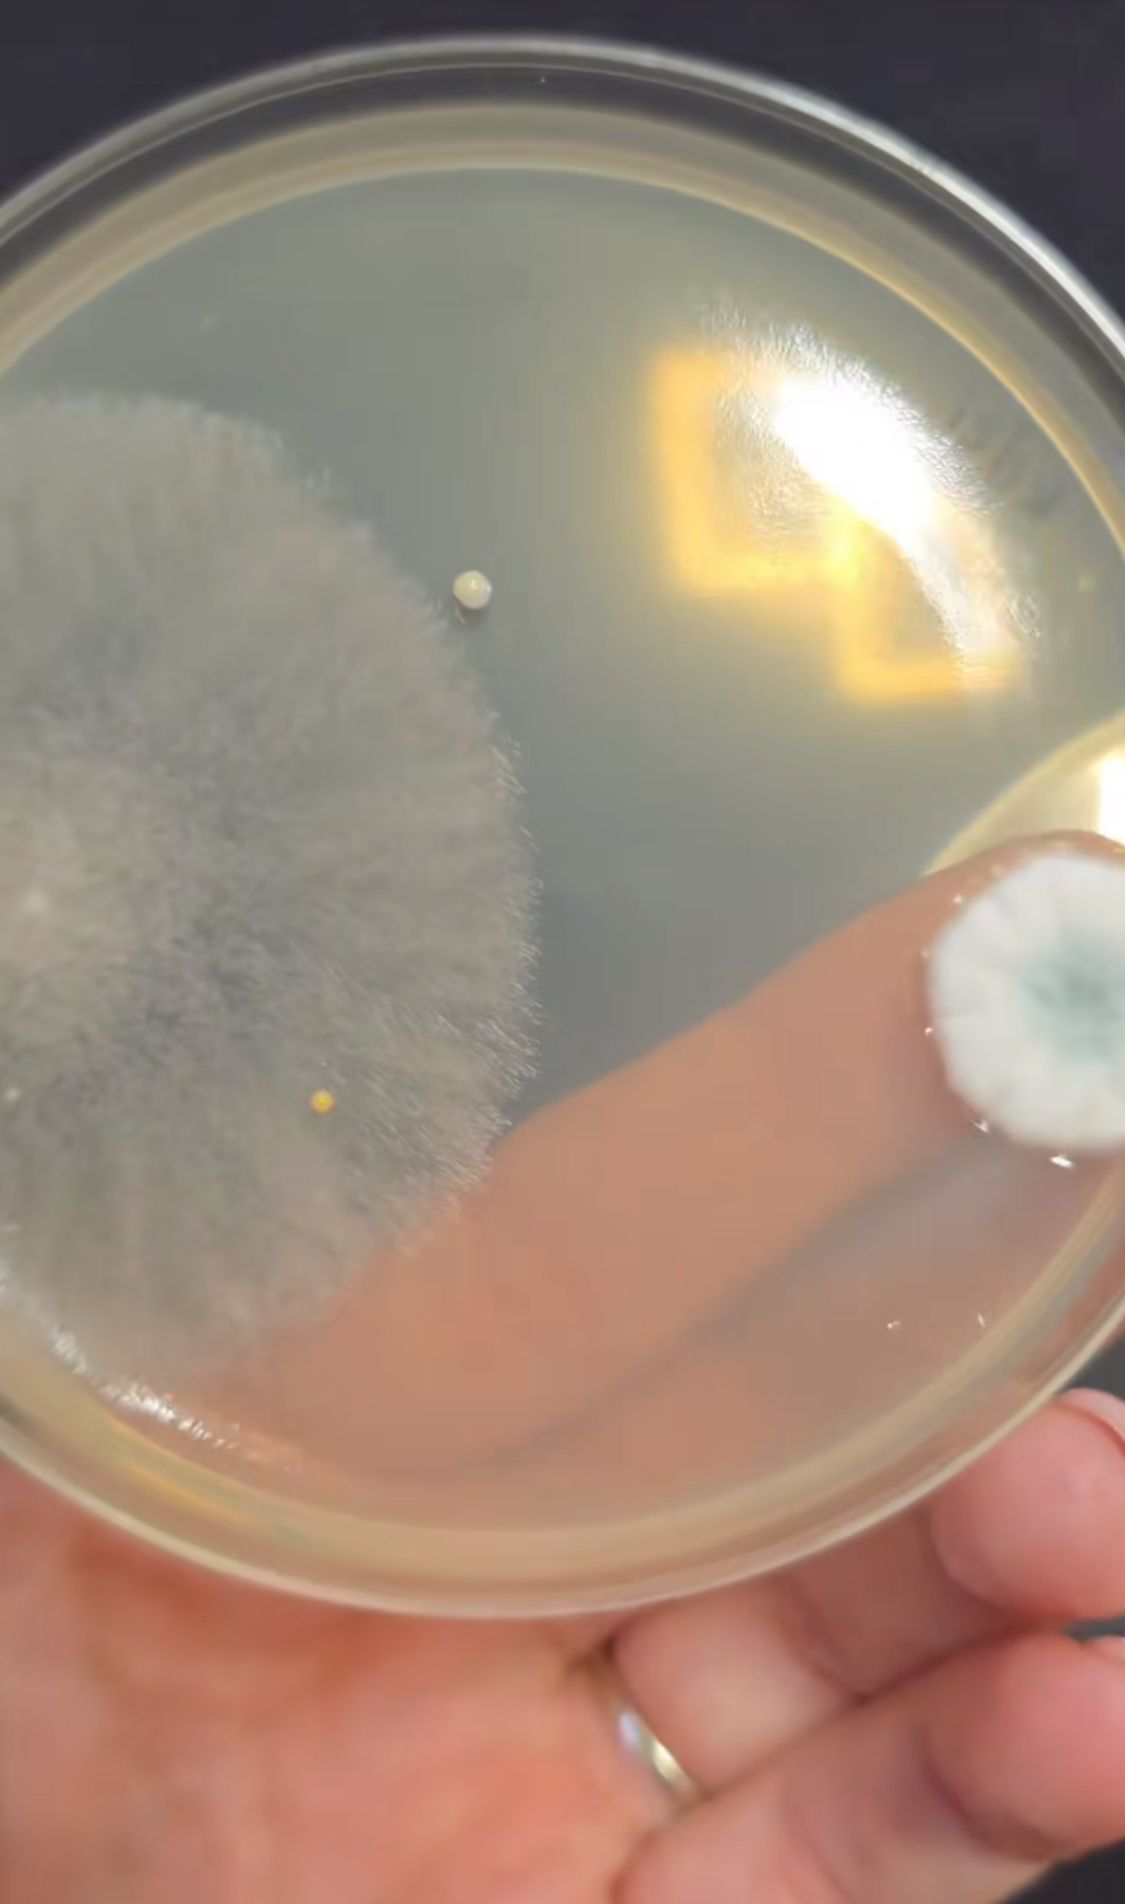
mosogatás
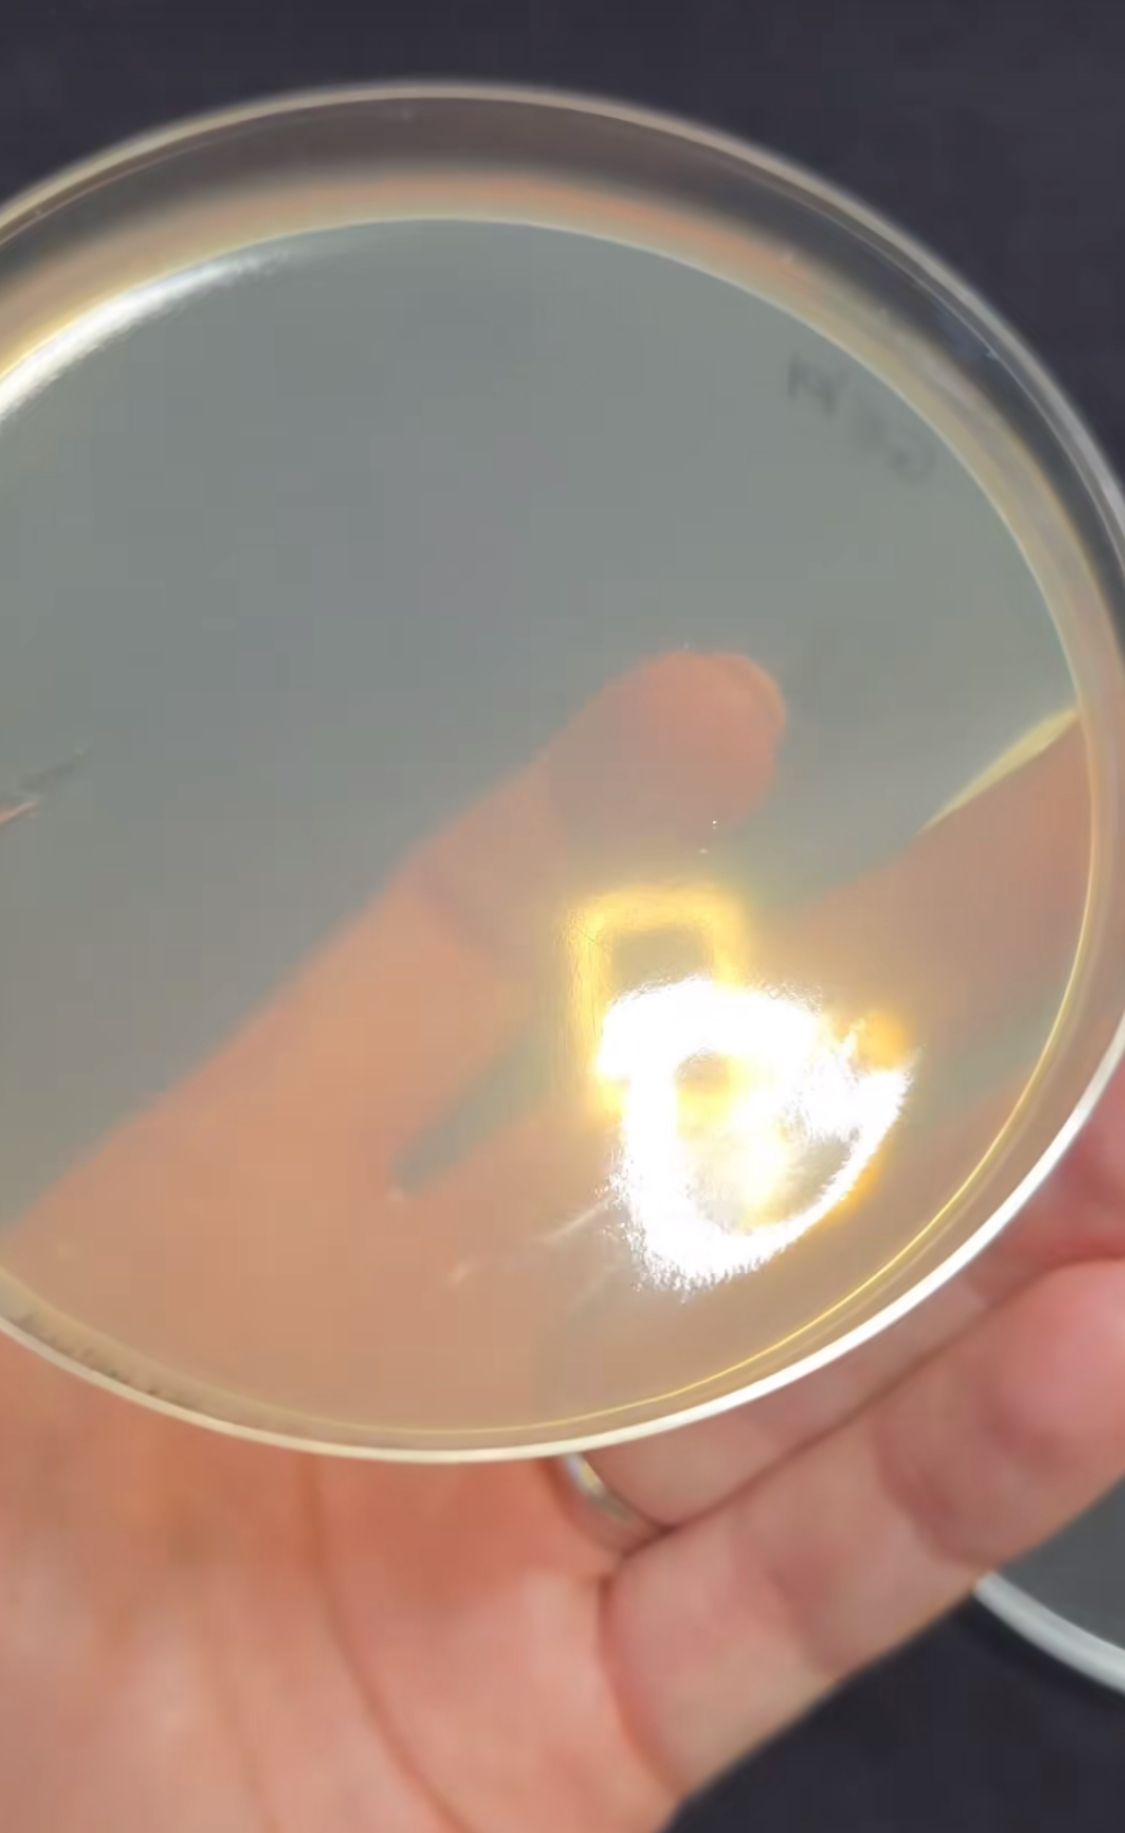

Varsói kutató bukkant rá az ufók nyomaira, itt rejtőzhetnek
Az ufók már az amerikai partoknál rejtőzhetnek.
Az eredmény megdöbbentő. A kézi és a gépi mosogatást hasonlította össze a növényorvos.
Újabb érdekes kísérlettel jelentkezett a TikTok kedvenc növényorvosa, Gyuris Rita. Korábban bemutatta már, hogy mennyire koszos a 4-es 6-os villamos, milyen gomba- és baktériumtelepek élnek egyes élelmiszereken, használati tárgyakon, vagy éppen az emberi bőrön. Most a kézi és a gépi mosogatás hatékonyságát hasonlította össze.
Rita két koszos villát használt a kísérlethez.
„Kézi mosogatás vagy mosogatógép? Melyik a hatékonyabb?” – tette fel a kérdést Gyuris Rita a TikTok-videójában.
Estére kapcsoltam be a mosogatógépet, mert öko programmal éjszaka mos; hogy össze tudjuk hasonlítani a kézi mosással, elmostam, majd letettem száradni, erről is csak reggel vettem mintát. Mindent úgy csináltam, mintha a való életben csináltam volna.
Rita egy speciális táptalajra, úgynevezett agar lemezre helyezte a mintát. Három különböző részre nyomta bele a villát. Három nap elteltével nézte meg az eredményeket:
A kézi mosogatás mintáján a nagy gombatelep valószínűleg felülfertőződés volt, tehát a levegőből kerülhetett valami a táptalajra, nem pedig a villáról. Két-három baktériumkolónia látszott a mintán, ami nem vészes, a villában pont meg tudnak bújni a kis ételmaradékok, mindenféle mikroorganizmus. Szerintem ez egy jó eredmény. A gépi mosogatáson ezzel szemben semmi nem nőtt fel. Nem lehet százszázalékosan azt mondani, hogy az egyik sokkal jobb, mint a másik, mert szerintem ez nem drasztikus különbség a kettő között. Hogyha egy kanalat vagy egy tányért vizsgáltam volna, valószínűleg nem is lenne különbség

Az ufók már az amerikai partoknál rejtőzhetnek.


Kissé etikátlan volt a viselkedése
Nem akar lemaradni a Metropol cikkeiről? Adja meg a nevét és az e-mail címét, és mi hetente három alkalommal elküldjük Önnek a legjobb írásokat!
Feliratkozom a hírlevélrePortfóliónk minőségi tartalmat jelent minden olvasó számára. Egyedülálló elérést, országos lefedettséget és változatos megjelenési lehetőséget biztosít. Folyamatosan keressük az új irányokat és fejlődési lehetőségeket. Ez jövőnk záloga.